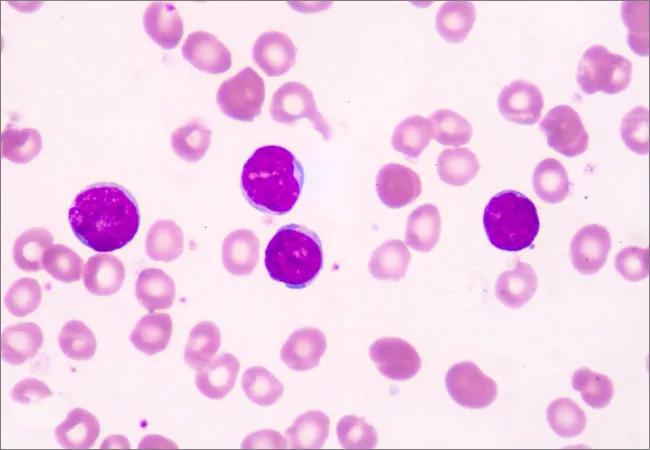

Drug beats standard care for the treatment of relapsed or refractory ALL
Image content: This image is available to view online.
View image online (https://assets.clevelandclinic.org/transform/1528a444-bb24-4408-9cee-afb147e488d0/ALL_650x450_jpg)
ALL_650x450
Inotuzumab ozogamicin (INO), an antibody-drug conjugate approved for the treatment of relapsed or refractory acute lymphoblastic leukemia (ALL), appears to be safer and more effective than standard care for patients with both higher and lower cluster of differentiation-22 (CD22) expression. A post-hoc analysis of the INO-VATE trial, recently published in Clinical Cancer Research, demonstrates the drug’s favorable benefit-risk profile when compared to standard care, independent of CD22 expression.
Advertisement
Cleveland Clinic is a non-profit academic medical center. Advertising on our site helps support our mission. We do not endorse non-Cleveland Clinic products or services. Policy
“Many potential treatments for adults with relapsed or refractory ALL have been studied, but very few have been approved by regulatory authorities in the past decade,” explains study author Anjali Advani, MD, Director of Cleveland Clinic Cancer Center’s Inpatient Leukemia Program. “Although INO was approved by the FDA in 2017 for the treatment of B-cell precursor ALL based on findings from the INO-VATE trial, it has been unclear whether patient responses correlate with CD22 expression of the leukemia cell.”
To address this knowledge gap, Dr. Advani and colleagues examined data from the trial to explore the connection between CD22 expression and outcomes in patients managed with INO.
The multicenter, randomized, phase III INO-VATE trial included adults with relapsed or refractory B-cell precursor CD22-positive ALL who were scheduled to receive their first or second salvage therapy. Enrolled patients were randomized 1:1 to receive INO (n=164) or standard care (n=162).
In general, baseline characteristics were balanced between the two treatment groups. In the intent-to-treat population, the median leukemic blast CD22 positivity at baseline was 98% for both INO and standard care groups. Most patients in both treatment cohorts had high (≥90%) leukemic blast CD22 positivity, with only a small portion showing leukemic blast CD22 positivity below 70%.
The research team analyzed outcomes by baseline CD22 positivity (percentage of leukemic blasts CD22 positive, ≥90% vs. <90%) and CD22 receptor density. The INO-VATE trial was initiated in August 2012 and ended in January 2017. Final data were used for the post-hoc analysis.
Advertisement
The majority of patients in the study had high (>=90%) CD22 positivity. A significantly higher response rate was observed in those being treated with INO than in patients managed with standard care. The response rate among patients with higher (≥90%) CD22 positivity was 78.5% for INO versus 35.5% for standard care. In patients with lower (<90%) CD22 positivity, the response rate of INO treatment was 65.7% compared to 30.6% for standard care.
Although responses and minimal residual disease negativity were seen at all levels of CD22 expression, improved outcomes related to specific endpoints were noted in patients with higher levels of the molecule.
The safety population included a total of 307 patients. Hematologic complications were the most common severe adverse events in both treatment groups. Hepatic adverse events of any grade were more common in patients who received INO. The study authors observed no apparent relationship between the rates of hematologic and hepatic adverse events and CD22 expression.
With the ongoing introduction of new novel therapies, efforts to identify better disease indicators and prognostic factors remain a top priority. Findings from the INO-VATE trial shed further light on INO and its efficacy for managing patients with relapsed/refractory ALL.
INO demonstrated a favorable benefit-risk profile for patients with relapsed or refractory B-cell precursor ALL, regardless of CD22 positivity. The data suggest that patients with leukemic blast CD22 positivity of 90% or greater derive deeper benefits from the medication, including minimal disease negativity, a longer duration of remission, and improved progression-free and overall survival.
Advertisement
According to Dr. Advani, these findings could play a pivotal role when initiating treatment for ALL. “Although benefits were observed in all groups, patients with high CD22 expression and normal cytogenetics appear to derive the most benefit from INO therapy. This data may affect decisions when other treatment options, including blinatumomab, are available for patients with lower levels of CD22 expression.”
Advertisement
Advertisement
Research underscores the importance of access to timely diagnosis and treatment in this patient population.
A Cleveland Clinic model combining clinical staging, genomics and AI predicts survival with 18% greater accuracy — and could help match patients to more effective treatments.
Study serves as ‘cautionary tale’ for physicians tempted to rely on liquid biopsy results alone
Direct delivery of viral-based vector KB707 to the lungs may boost anti-tumor response and help overcome immune checkpoint inhibitor resistance
Evidence-based recommendations for managing pain, nausea and other treatment reactions
Emerging data and practice changes reduce toxicity burden of treatment
Understanding supports for adolescent and young adult patients
Reframing cancer survivorship